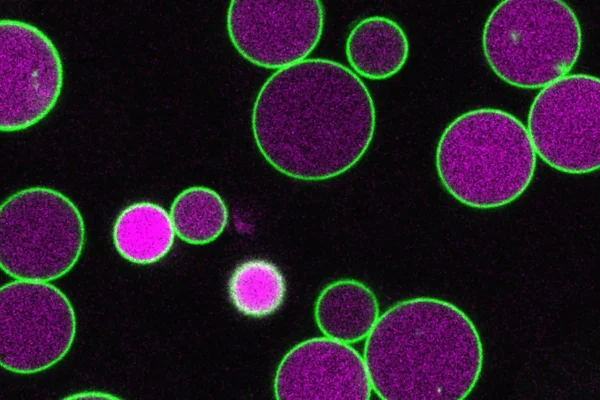

Scientists just found what keeps plant cells from growing out of control
Plants spend most of their lives using photosynthesis to make energy. However, in the earliest phase after a seed begins to grow, they cannot yet capture light. During this short but critical window, they depend on stored fatty acids instead. To break down these fatty acids, plant cells use a specialized structure known as the…








